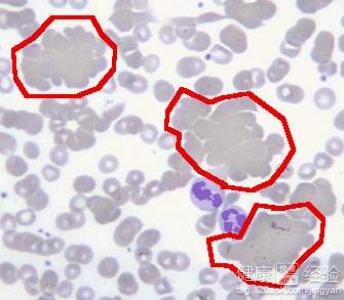
第1步

溶血症,不是新生兒溶血症!是小兒溶血症(出生77天)怎麼治療
概 述
小兒溶血症的出現與夫妻雙方的血液不合有關系,所以在做婚檢的時候可以查出來,但是不能完全保證婚檢沒事,但是懷孕後出現。同樣的做唐篩的時候可以檢測出來,但是概率就變小了,那麼發生這種情況以後我們應該如何進行治療,我相信這是廣大家長朋友關心的問題,前段時間我的朋友做過了檢查,醫生給做了一些治療,下面我來跟大家分享一下心得,方便大家在以後的治療過程中加以注意。
步驟/方法:
1首先是要注意O型血的媽媽在做血液檢查的時候要格外注意,小兒溶血症主要發生在0型血的情況下,這時候要注意加驗是否有發生溶血症的概率。這樣可以保證我們的孩子發生小兒溶血症的幾率變成最小,另外孩子的身體健康也能夠得到保障,所以我們應該提高警惕,在醫生的指導下進行檢查。
2如果確診為小兒溶血症,那麼可以采用中西醫結合的方法來進行治療,所以廣大媽媽不要過度擔心,運用非激素非輸血免疫平衡療法,這種是集合中醫療法溶血,能夠迅速清除免疫因子,抑制變態反應,從一定程度上可以抑制溶血的發生,所以我們應該到正規專業的醫院進行檢查,避免耽誤病情。

3最後是要注意後期的病情跟蹤,因為孩子出現這種小兒溶血症的話,很容易造成心理上和身體上出現問題,比如出現冷凝集素,病情常反復,再有就是病毒感染就是常見的一種誘發因素,所以我們要及時根據孩子的身體狀況選擇大醫院進行治療,定期復查。
注意事項:
還有就是要注意平時避免孩子服用刺激血液的一些食物,比如辛辣或者是激發體內血液流動迅速的食物,同時要注意讓孩子休息好,避免過度的體育運動,這樣可以幫助體內形成一個保護膜,減少疾病發生的概率,同時還要做好孩子的營養衛生。
- 關於新生兒
-
嬰兒車電梯上仰翻 寶寶安全乘電梯
導語近日在漢口地鐵2號線發生驚心一幕,兩位老人推著一輛嬰兒車乘
-
寶寶7個月還沒長牙,也不流口水,急!
寶寶7個月還沒長牙,也不流口
-
怎麼樣預防小兒的濕疹?
概 述 濕疹是小兒時期的一種常見疾病,如
-
寶寶十個月了秋季腹瀉剛好,又開始啦綠色大
寶寶十個月了秋季腹瀉剛好,又開始啦綠色大 男1歲來自山東





